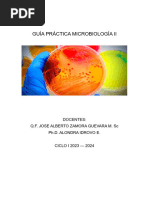

0% encontró este documento útil (0 votos)
107 vistas1 páginaGuía Informe Seminarios Microbiología
Este documento proporciona instrucciones para la presentación de un informe de seminario sobre microbiología industrial de alimentos. Debe contener una portada con el título y nombres del grupo, un resumen de 3 palabras clave, un índice, el desarrollo del tema con subtítulos, posibles perspectivas y conclusiones, y referencias bibliográficas. Se recomienda utilizar letra Arial 11 con interlineado 1,5 y revisar un artículo específico como modelo.
Cargado por
juan carlosDerechos de autor
© Attribution Non-Commercial (BY-NC)
Nos tomamos en serio los derechos de los contenidos. Si sospechas que se trata de tu contenido, reclámalo aquí.
Formatos disponibles
Descarga como DOC, PDF, TXT o lee en línea desde Scribd
0% encontró este documento útil (0 votos)
107 vistas1 páginaGuía Informe Seminarios Microbiología
Este documento proporciona instrucciones para la presentación de un informe de seminario sobre microbiología industrial de alimentos. Debe contener una portada con el título y nombres del grupo, un resumen de 3 palabras clave, un índice, el desarrollo del tema con subtítulos, posibles perspectivas y conclusiones, y referencias bibliográficas. Se recomienda utilizar letra Arial 11 con interlineado 1,5 y revisar un artículo específico como modelo.
Cargado por
juan carlosDerechos de autor
© Attribution Non-Commercial (BY-NC)
Nos tomamos en serio los derechos de los contenidos. Si sospechas que se trata de tu contenido, reclámalo aquí.
Formatos disponibles
Descarga como DOC, PDF, TXT o lee en línea desde Scribd